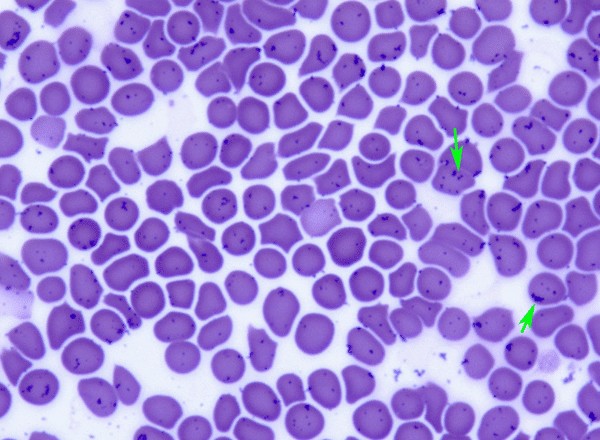

chevron_leftTous les services
Laboratoire d'analyses
Un laboratoire complet pour des résultats immédiats, précis et ultra fiable.
Nous sommes équipés d'un laboratoire complet d'analyses médicales ; ces équipements techniques de référence et de pointe (laboratoires IDEXX et VIRBAC) permettent un large panel d'analyses sanguines et urinaires adapté et configuré pour les animaux domestiques.
- Numération formule sanguine
- Biochimie (rénale, hépatique, pancréatique, inflammatoire...)
- Dosages hormonaux
- Temps de coagulation
- Analyses urinaires
- détection de maladies infectieuses
- examens microscopiques (dermatologie, urologie, parasitaires ...) couplée à l'IA pour certaines analyses pour une détection simplifiée et performante
- cytologie de masse/nodule (nouveau) par IA en complément de celle du vétérinaire